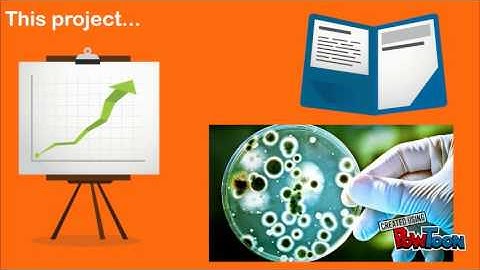
Artificial cell

⬇ DOWNLOAD NOW
Kalau muncul iklan pop-up, tutup lalu klik tombol kembali
Download lagu Artificial cell on chip secara gratis hanya untuk keperluan promosi. Dukung artis favorit kamu dengan membeli musik original di iTunes atau platform resmi lainnya.
 An Artificial Cell On-A-Chip
An Artificial Cell On-A-Chip
 Artificial "cells" that move like the real thing
Artificial "cells" that move like the real thing
 Scientists Build Artificial Cell That Can Grow and Divide Like a ‘Real’ One
Scientists Build Artificial Cell That Can Grow and Divide Like a ‘Real’ One
 Artificial Cell Mimics “Eating” E. coli Bacteria
Artificial Cell Mimics “Eating” E. coli Bacteria
 Microfluidics for bottom-up assembly of synthetic cells
Microfluidics for bottom-up assembly of synthetic cells
 NanoNextNL Cell membrane on a chip
NanoNextNL Cell membrane on a chip
 Synthetic Cell Initiative - Jean-Christophe Baret on making cells that produce new materials
Synthetic Cell Initiative - Jean-Christophe Baret on making cells that produce new materials
Artificial cell
Artificial cell